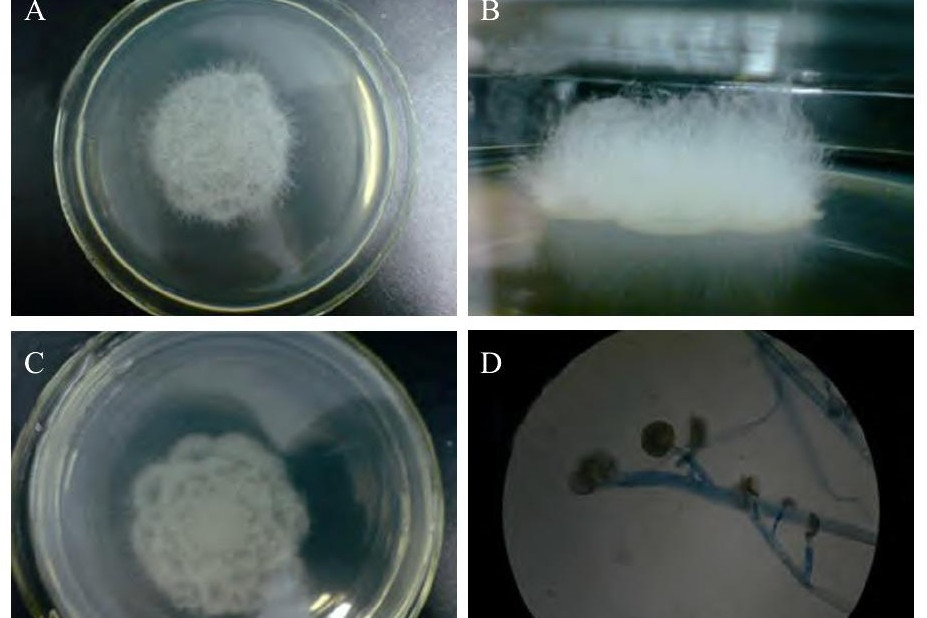
data-id="gnf8gze4ct">犁头霉属(absidia),真菌界,真菌门,接合菌亚门

接合菌亚门

接合菌亚门
图片尺寸1060x575
接合菌亚门(菌物)_技点知识_技点网(菌物)
图片尺寸848x924
接合菌
图片尺寸300x237
接合菌亚门
图片尺寸755x838
接合菌亚门真菌zygomycotina_第2页
图片尺寸920x690
2,接合菌亚门
图片尺寸595x450
植物病原真菌接合菌亚门真菌_第3页
图片尺寸1509x1131
接合菌亚门的学习教案_第3页
图片尺寸1500x1125
植物病原真菌接合菌亚门真菌_第2页
图片尺寸1509x1131
接合菌亚门真菌zygomycotina_第3页
图片尺寸920x690
植物病原真菌接合菌亚门真菌_第5页
图片尺寸1509x1131
第三节 接合菌亚门真菌 ( zygomycotina ) 有性生殖产生接合孢子,.
图片尺寸680x510
【农学课件】第五章 接合菌亚门.ppt
图片尺寸1152x864
data-id="gnf8gze4ct">犁头霉属(absidia),真菌界,真菌门,接合菌亚门
图片尺寸927x618
植物病原真菌接合菌亚门真菌_第1页
图片尺寸1509x1131
接合菌亚门真菌(zygomycotina)ppt
图片尺寸1080x810
接合菌亚门精要.pptx 17页
图片尺寸1152x864
鞭毛菌亚门和接合菌亚门课件_第1页
图片尺寸1500x1125
植物病原接合菌亚门观察
图片尺寸920x1302
接合菌亚门zygomycotina
图片尺寸800x600